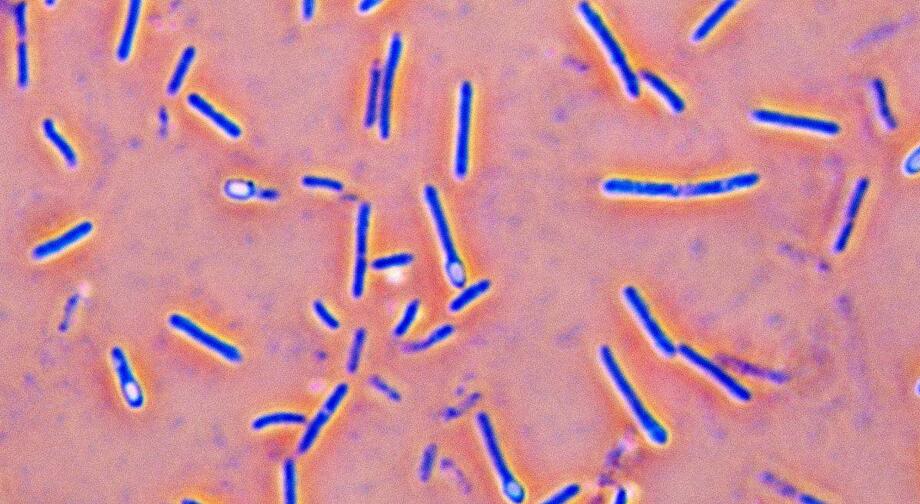

芽孢
形态
某些细菌(芽孢杆菌,梭状芽孢杆菌,少数球菌等)在其生长发育后期,在细胞内形成的一个圆形或椭圆形,厚壁,含水量低,抗逆性强的休眠体构造,称为芽孢。
在不同细菌中,芽孢所处的位置不同,有的在中部,有的在偏端,有的在顶端。芽孢一般呈圆形、椭圆形、圆柱形。在有些细菌中,芽孢的直径小于菌体直径,这些细菌称坚强芽孢杆菌在逆境环境中的芽孢生成过程。
芽孢杆菌,为好氧细菌;在另一些细菌中,芽孢的直径大于菌体直径,使整个菌体呈梭形或鼓塑形,这些细菌称为梭状芽孢杆菌,为厌氧菌,梭状芽孢杆菌的芽孢位于菌体中间。破伤风杆菌的芽孢位于菌体的一端,使菌体呈鼓槌状。好氧芽孢杆菌属(Bacillus)和厌氧的梭状芽孢杆菌属(Clostridium)的所有细菌都具有芽孢。在球菌和螺菌中,只有少数种类有芽孢,球菌中只有芽孢八叠菌(Sporosarcina)属产芽孢。弧菌中只有芽孢弧菌属(Sporovibrio)产芽孢。
芽孢形成
芽孢的形成是一个极其复杂的过程,包括形态结构、化学成分等多方面的变化。
光学显微镜和电子显微镜观察研究的结果,表明芽孢的形成在结构上主要经历以下几个阶段:①核物质融合成轴丝状(杆状)。②在细胞中央或一端,细胞膜内陷形成隔膜包围核物质,产生一个小细胞。③小细胞被原来的细胞膜包围,生成前孢子。前孢子实质上是一个被两层同心膜包围着的原生质体。在光学显微镜下观察未染色的活细菌,可以看到前孢子是一个清亮的、与菌体其他部分明显不同的区域。④前孢子再被多层膜包围,如皮层、孢子衣等,最后成为成熟的芽孢,由于细胞壁的溃溶而释放出来。
芽孢结构
芽孢的结构相当复杂,最里面为核芯(core),含原生质体,被芽孢膜(spore membrane)所包裹。核芯外面为皮层(cortex),成分为肽聚糖,再往外是一层或数层蛋白质组成的芽孢壳(spore coat),最表面为芽孢壁(spore wall),也称芽孢外壁(exosporium)。

特性
综述
由于芽孢在结构和化学成分上均有别于营养细胞,所以芽孢也就具有了许多不同于营养细胞的特性。芽孢最主要的特点就是抗性强,对高温、紫外线、干燥、电离辐射和很多有毒的化学物质都有很强的抗性。同时,芽孢还有很强的折光性。在显微镜下观察染色的芽孢细菌涂片时,可以很容易地将芽孢与营养细胞区别开,因为营养细胞染上了颜色,而芽孢因抗染料且折光性强,表现出透明而无色的外观。研究表明芽孢对不良环境因子的抗性主要由于其含水量低(40%)。且含有耐热的小分子酶类,富含大量特殊的吡啶二羧酸钙和带有二硫键的蛋白质,以及具有多层次厚而致密的芽孢壁等原因。
自由存在的芽孢没有明显的代谢作用,只保持潜在的萌发力,称为隐藏的生命。一旦环境条件合适,芽孢便可以萌发成营养细胞。
细菌芽孢特点
整个生物界中抗逆性最强的生命体,在抗热,抗化学药物和抗辐射等方面,十分突出。
例如,肉毒梭菌的芽胞在沸水中要经过5至9.5h才被杀死;巨大芽胞杆菌芽胞的抗辐射能力比E.coli细胞要强36倍。芽胞的休眠能力更为突出,在常规条件下,一般可以保持几年至几十年而不死。据文献记载,有的芽胞甚至可以休眠数百至数千年,最极端的例子是在美国的一块有2500万~4000万年历史的琥珀,至今从其中蜜蜂肠道内还可以分离到有生命的芽胞。
是否能消灭芽孢是衡量各种消毒灭菌手段的最重要的指标。
芽孢是细菌的休眠体,在适宜的条件下可以重新转变成为营养态细胞;
产芽孢细菌的保藏多用其芽孢。产芽孢的细菌多为杆菌,也有一些球菌。
芽孢的有无、形态、大小和着生位置是细菌分类和鉴定中的重要指标。
芽孢与营养细胞相比化学组成存在较大差异,容易在光学显微镜下观察。(相差显微镜直接观察;芽孢染色)
特点描述
1.芽孢的含水率低,38%~40%。
2.芽孢壁厚而致密,分三层:外层是芽孢外壳,为蛋白质性质。中层为皮层,由肽聚糖构成,含大量2,6-吡啶二羧酸。内层为孢子壁,由肽聚糖构成,包围芽孢细胞质和核质。芽孢萌发后孢子壁变为营养细胞的细胞壁。
3.芽孢中的2,6-吡啶二羧酸(dipicolinic acid 简称DPA)含量高,为芽孢干重的5%~15%。吡啶二羧酸
以钙盐的形式存在,钙含量高。在营养细胞和不产芽孢的细菌体内未发现2,6-吡啶二羧酸。芽孢形成过程中,2,6-吡啶二羧酸随即合成,芽孢就具有耐热性,芽孢萌发形成营养细胞时,2,6-吡啶二羧酸就消失,耐热性就丧失。
4.含有耐热性酶。
芽孢由于有以上四个特点,是芽孢对不良环境如:高温、低温、干燥、光线和化学药物有很强的抵抗力。细菌的营养细胞在70~80℃时10分钟就死亡,而芽孢在120~140℃还能生存几小时,营养细胞在5%苯酚溶液中很快就死亡,芽孢却能存活15天,芽孢的大多数酶处于不活动状态,代谢活力极低,所以,芽孢是抵抗外界不良环境的休眠体。

5.伴孢晶体(spore-companioned crystal)
芽孢杆菌属中有些种如苏云金芽孢杆菌、杀螟杆菌等在形成芽孢的同时,在细胞内产生一种晶状多肽类内含物,称伴孢晶体,一个细菌一般只产生一个伴孢晶体,它呈斜方形、方形或不规则形。伴孢晶体是一种毒性晶体,对很多昆虫主要是鳞翅目的昆虫有毒害作用,对人畜毒性很低,是一种较为理想的杀虫剂。
芽孢不易着色,但可用孔雀绿染色。
耐热机制
主要介绍
关于芽孢耐热的本质至今尚无公认的解释。较新的是渗透调节皮层膨胀学说。渗透调节皮层膨胀学说:芽孢衣对多价阳离子和水分的透性很差皮层的离子强度很高,产生极高的渗透压夺取芽孢核心的水分,结果造成皮层的充分膨胀。核心部分的细胞质却变得高度失水,因此,具极强的耐热性。除渗透调节皮层膨胀学说外,还有别的学说来解释芽孢的高度耐热机制。例如,针对在芽孢形成过程中会合成大量的为营养细胞所没有的DPA-Ca,该物质会使芽孢中的生命大分子物质形成稳定而耐热性强的凝胶。总之,芽孢耐热机制还有待于深入研究。
芽孢的萌发
刚形成的芽孢总是处于休眠状态。热处理(如65℃放置几十分钟)可以使芽孢加速活化。低温贮藏也有活化作用,只是较慢。
芽孢萌发时首先发生吸胀作用,随之折光性和抗性丧失,继而呼吸作用开始,显出代谢活性,芽孢物质(干重)的30%变为可溶物释出,营养细胞壁迅速合成,最后,新形成的营养细胞从孢子衣里萌发出来。萌发通常有三种方式:赤道脱出,末端脱出,斜出。
其他休眠结构
少数细菌还产生其他休眠状态的结构,如固氮菌的孢囊等。固氮菌在营养缺乏的条件下,其营养细胞的外壁加厚、细胞失水而形成一种抗干旱但不抗热的圆形休眠体——孢囊,与芽孢一样,也没有繁殖功能。在适宜的外界条件下,孢囊可萌发,重新进行营养生长。
本质
芽孢细菌的繁殖都是等分横裂的,一个母细胞产生两个子细胞。在其分裂的过程中并没有芽孢的产生;而且,当产生芽孢时,一个细菌只产生一个芽孢,并没有数量的增加。
一般认为,芽孢是在生长后期、营养物质缺乏时形成的,因而是适应不良环境的产物。但实际上,可能不完全是如此。有人在培养枯草芽孢杆菌时,曾作过追踪观察。结果发现,在接种培养4小时后即有芽孢生成。以后每隔4小时观察一次,芽孢数均呈比例增长。至24小时,约半数产生芽孢;48小时,全部变成芽孢。这种情况表明,在此情形下营养细胞转向芽孢形成有一定的概率。芽孢开始形成不必等到生长后期,更不必等到生长完全停止。
因此,芽孢形成既不是细菌生活周期的必经阶段,也不是细菌繁殖的一种形式,又不是一种消极的对环境的反应,而是一个新器官的积极生成。决定芽孢形成的根本原因在于细菌内部,细菌染色体上有控制芽孢形成的基因。细菌在营养生长中,这些基因通常不表达,它们可能被一个阻遏体系所控制,一旦这一阻遏消除,就可导致芽孢形成。
有时人们把芽孢与荚膜、鞭毛等并列,统称为细菌的特殊结构,这一称呼也值得商榷。因为在正常生长中的营养细胞本身并没有芽孢,而当芽孢形成后,营养细胞就不复存在。虽然在有些菌类,芽孢形成后还有部分菌体残存,但这时的菌体已丧失了营养细胞的作用,不能再象无芽孢时的菌体那样进行生命活动。而荚膜和鞭毛就不同了,它们不影响细菌的生命活动,伴随着营养细胞的生存而存在。因此,把芽孢看成是一种独立的休眠体,是一种积极产生的新的生命形式或新器官,或许是恰当的。
作用
1.分类鉴定不同细菌的芽孢具有不同的特点,从形状、大小、表面特征,直到与菌体的关系等都有不同的表现,因此可以作为分类鉴定的依据或参考。
2.科研材料 由于芽孢独特的产生方式,成为研究形态发生和遗传控制的好材料。
3.保存菌种芽孢对不良环境有很强的抵抗力,可以保持生命力达数十年之久,在自然界使细菌度过恶劣的环境,在实验室是保存菌种的好材料。
4.分离菌种芽孢的耐热性有助于芽孢细菌的分离。将含菌悬浮液进行热处理,杀死所有营养细胞,可以筛选出形成芽孢的细菌种类。
5.生物杀虫有些芽孢细菌在产生芽孢的同时,可以产生一种双锥形的结晶内含物,称为伴孢晶体,这是一种蛋白质毒素,可以杀死某些昆虫(特别是鳞翅目)的幼虫。蛋白质晶体的毒性是有高度专性的,对其他动物与植物完全没有毒性。因此,它们便成为一种理想的生物杀虫剂,这种杀虫剂的生产,并不需将蛋白质分离出来,只需培养大量细菌,在其形成芽孢并产生晶体时收获、干燥,做成粉剂即可。
6.研究芽孢的意义研究细菌芽孢有着重要的理论和实践意义。①芽孢的有无、形态、大小和着生位置等是细菌分类和鉴定中的重要形态学指标;②这类菌种芽孢的存在,有利于提高菌种的筛选效率,有利于菌种的长期保藏;③是否能杀灭一些代表菌的芽孢是衡量和制定各种消毒灭菌标准的主要依据;④许多产芽孢细菌是强致病菌。例如,炭疽芽孢杆菌、肉毒梭菌和破伤风梭菌等;⑤有些产芽孢细菌可伴随产生有用的产物,如抗生素短杆菌肽、杆菌肽等。
芽孢可度过不良环境,对干旱和高、低温都有极强的抵抗力。条件转好时,1个芽孢可形成1个细菌细胞。有些细菌的芽孢,在干燥条件下,可保持10多年或更长的时间仍能萌发,有的能忍耐-253℃的低温,有的在沸水中煮30小时后仍有生活力,但也有的芽孢在80~90℃下几分钟即死亡。因此,外科手术或注射器的消毒,一定要用高压灭菌。能形成芽孢的细菌为杆菌科中的梭状芽孢杆菌属和芽孢杆菌属的所有种类。此外,还有少数螺旋菌、孤菌和八叠球菌等属的种类。研究芽孢的形成和萌发,具有重要的理论和实践意义。因为有些能形成芽孢的细菌是人体的病原菌。在食品、医药,以及发酵工业都要彻底消灭细菌的芽孢。有些芽孢菌可用来杀灭害虫,如苏云金杆菌、青虫菌、杀螟杆菌等在形成芽孢时,还产生蛋白质伴胞晶体,对鳞翅目昆虫有强大的毒杀作用。因而将这些芽孢杆菌制成杀虫剂,实行以菌治虫,并称之为细菌农药。
危害
芽孢对人类也有有害的一面。最常见的情况之一,就是用加热法保存食品时,芽孢往往会造成保存的失败。这是因为芽孢极耐热,一般加热法不能把它杀死,它萌发成营养细胞后大量繁殖,会导致食品腐败变质。因此需要用高温间歇灭菌法把芽孢杀死,才能使食品长期保存。医疗器械也需经高温灭菌后才能保证安全。近几年发展起来的辐射灭菌法,其主要杀灭对象也是芽孢。
伴孢晶体
伴孢晶体(parasporal crystal)少数芽孢杆菌,例如苏云金芽孢杆菌(Bacillus thuringiensis)在其形成芽孢的同时,会在芽孢旁形成一颗菱形或双锥形的碱溶性蛋白晶体—δ内毒素,称为伴孢晶体。特点:不溶于水,对蛋白酶类不敏感;容易溶于碱性溶剂。伴孢晶体对200多种昆虫尤其是鳞翅目的幼虫有毒杀作用,因而可将这类产伴孢晶体的细菌制成有利于环境保护的生物农药——细菌杀虫剂。
参考文献
文章来源:百度百科及农夫百科
原始创建:佚名
词条概况
版本编辑:1次
最近更新:2018-01-26
历史浏览:7989次
最新编辑:佚名
原始创建:佚名



















